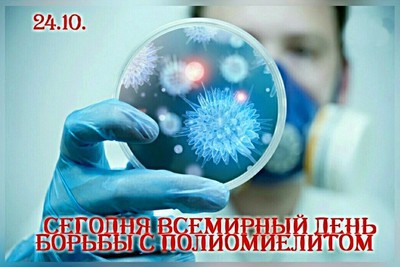
24 октября - Всемирный день борьбы с полиомиелитом

24 октября - Всемирный день борьбы с полиомиелитом
|
Полиомиелит(детский спинальный паралич) - острое инфекционное заболевание, вызываемое вирусами полиомиелита. Характеризуется поражением нервной системы (преимущественно серого вещества спинного мозга), что приводит к параличам мышц, может стать причиной развития дыхательной и сердечно-сосудистой недостаточности из-за паралича межреберных и диафрагмальных мышц. Паралич дыхательных мышц нередко становится причиной летального исхода. В основном, заболевание поражает детей в возрасте до 5 лет. На сегодняшний день полиомиелит не ликвидирован в глобальном масштабе, поэтому проблема завозных случаев заболевания остается актуальной. Передается полиомиелит фекально-оральным путем, реже – воздушно-капельным. В целях профилактики полиомиелита проводится иммунизация детей, начиная с самого раннего возраста. В России прививки против полиомиелита входят в Национальный календарь профилактических прививок, утвержденный приказом Министерства здравоохранения Российской Федерации от 21 марта 2014 г. № 125н., согласно которому всем детям необходимо сделать 6 прививок от полиомиелита (в 3; 4,5; 6; 18; 20 месяцев и в 14 лет). Первые две вакцинации, вне зависимости от возраста, проводятся инактивированной вакциной (ИПВ), которая содержит убитые вирусы 1,2,3 типов, вводится с помощью инъекции. Последующие прививки (вакцинация и ревакцинации) проводятся живой вакциной (ОПВ), которая содержит живые ослабленные вирусы 1 и 3 типов, вводится перорально (закапывается в рот). Живая полиомиелитная вакцина имеет принципиальное отличие от инактивированной, которое заключается в том, что, вирус размножается в кишечнике, выделяется с фекалиями и может передаваться людям при близком контакте. Однако благодаря такому «кишечному иммунитету» ОПВ является единственным эффективным средством защиты и остановки передачи полиовируса при выявлении вспышки заболевания. Дети, привитые живой полиомиелитной вакциной, выделяют вирус в окружающую среду (с фекалиями) в течение около 60 дней. При несоблюдении правил личной гигиены, особенно в организованных детских коллективах, вирус может попасть на руки, одежду других восприимчивых к нему детей (не привитых), на игрушки и другие предметы, которыми пользуются такие дети, и вызвать у них заболевание, в связи с чем действующими санитарными правилами предусмотрено разобщение не привитых детей от привитых сроком на 60 дней. Противопоказания к проведению вакцинации определяет только врач. Всемирная организация здравоохранения (ВОЗ) рекомендует путешественникам, отправляющимся в страны, эндемичные по полиомиелиту, иметь полную вакцинацию против полиомиелита. Если взрослый никогда не был привит против полиомиелита, то выезжая в страны, неблагополучные по полиомиелиту ему рекомендуется пройти трехкратную иммунизацию против полиомиелита. Возможны ли побочные эффекты вакцинации? Вакцины против полиомиелита - одни из самых безопасных и эффективных. Реакция на вакцинацию практически отсутствует. В крайне редких случаях возможно временное повышение температуры тела на 5-14 день после прививки. Применение вакцины ОПВ для первых двух вакцинаций (в нарушение национального календаря профилактических прививок) может привести к возникновению у привитого вакциноассоциированного полиомиелита (ВАПП), особенно, при наличии у него иммунодефицитного состояния. Кроме того, ВАПП может возникнуть у не привитых лиц, которые находились в тесном контакте с только что привитым ребенком на протяжение 60 дней с момента его иммунизации (в семье. В организованном коллективе). Живая полиомиелитная вакцинане применяетсяу детей из групп риска (с иммунодефицитными состояниями), а также в случае, если в семье (в тесном контакте) есть другой ребенок, не имеющий прививок против полиомиелита при отсутствии возможности исключения их контакта на период 60 дней.. Частота развития ВАПП чрезвычайно невелика, 2-4 случая на 1 млн новорожденных (по данным ВОЗ). Приходится в основном на детей с выраженными нарушениями иммунитета и с тяжелыми хроническими заболеваниями. Следует помнить, что риск, связанный с побочным действием вакцины, в десятки тысяч раз меньше риска заболевания полиомиелитом ребенка, не имеющего прививок против полиомиелита. |
 Версия для слабовидящих
Версия для слабовидящих 





